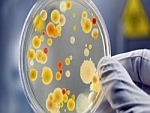

Новости
30 Июня 2015
На московоском портале “Активный гражданин” появился раздел, где москвичи могут поставить баллы за понравившееся городское коммунальное нововведение.
0
29 Июня 2015
Более 370 тысяч рублей задолженности за жилищную услугу в течение одной только недели погасили орловчане после оповещений операторов Единой диспетчерской службы. Полностью оплатили имеющуюся задолженность десять человек.
0
26 Июня 2015
В Советском районе Орла, как и в других районах города, подготовка к отопительному периоду 2015-2016 находится в активной стадии.
0
25 Июня 2015
0
25 Июня 2015
24 июня 2015 года в Минстрое России обсудили проект постановления Правительства РФ «Об утверждении требований по приспособлению жилого помещения с учетом потребностей инвалидов». Совещание прошло совместно с представителями заинтересованных общественных организаций, профильными ведомствами и застройщиками.
0
24 Июня 2015
22 июня в Единой диспетчерской службе зафиксировали рекордное количество обращений за последние недели. В этот день жители позвонили по телефону 510-510 829 раз. Для сравнения: на следующий день, во вторник, поступило 616 звонков.
0
24 Июня 2015
ООО «ИНТЕР РАО – Новосибирский энергосбыт» отключило от электроснабжения офис муниципальной управляющей компании – МУП ЖРЭП (Заказчик), сообщает энергокомпания.
0
24 Июня 2015
Ведущий юрист-консульт направления "Городское хозяйство" фонда "Институт экономики города" Дмитрий Гордеев предложил ввести субсидиарную ответственность за долги по нсо для собственников жилья в многоквартирных домах (МКД). Подобные меры помогут повысить ответственность многочисленных должников.
0
24 Июня 2015
Компания из Краснодара разработала технологию очистки труб отопления с помощью специально выведенных штаммов бактерий. Проект победил в конкурсе Startup Village, который проводит "Сколково". В скором времени проект будет реализован в столичных домах.
0
23 Июня 2015
В доме № 62 по улице Раздольной закончились масштабные восстановительные работы наружной боковой стены панели лоджии на 10-м этаже. К ним были привлечены промышленные альпинисты.
0
|
 Бюджетный надзор
Бюджетный надзор